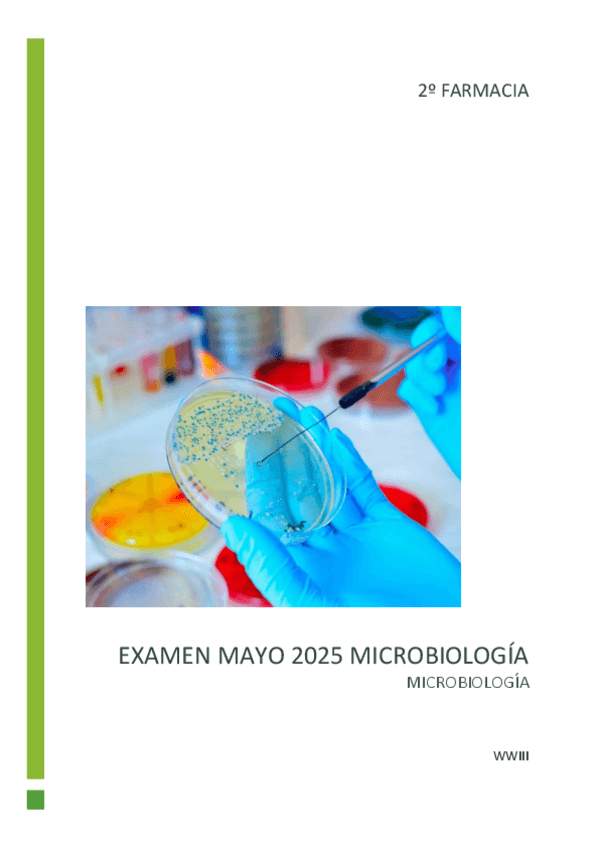

@WWIII04
Bio: Tercer año de Farmacia, adoro las neuronas que recupero al leer tremendos factos
70 Publicaciones
2.21k Interacciones
6 Seguidores
3 Siguiendo
Lista de publicaciones de WWIII04
Autoevaluación + examen 2020 + examenes de autoevaluación
Recopilatorio preguntas socrative que suele poner en el examen
examenes
-
Recopilatorio Fisio Humana III
Dos PDFs de preguntas
Recopilatorio de preguntas test, desarrollo y problemas de otros años con definiciones
examenes
-
BIOQUÍMICA I Y II
He publicado nuevos examenes de 2º Bioquímica y Biología Molecular: BIOQUÍMICA I Y II
He publicado nuevos examenes de 2º Ética: PREGUNTAS-ETICA-MAYO-2025-2.pdf
examenes
-
MINITESTS
son 3
Tests y algunas preguntas de Gamazo que tiene pinta de ser cables, (cuando hicimos el examen eran parecidos)
examenes
-
FISIO Y FISIOPATO II
He publicado nuevos examenes de 2º Fisiología y Fisiopatología II: FISIO Y FISIOPATO II
apuntes
-
Apuntes - Temas 7 - 8 - 9 - 10 - 11 - 12
He publicado nuevos apuntes de 2º Ética: Apuntes - Temas 7 - 8 - 9 - 10 - 11 - 12
Recopilación de evaluaciones continua y de algunas preguntas de wooclap
apuntes
-
Apuntes temas 1 - 2 - 3 - 4 - 5 - 6
La profesora es nueva, ósea que subo mis apuntes por acá